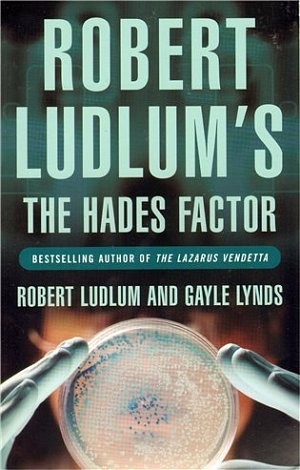
The Hades Factor

| Nakladatel: |
Orion Publishing Co |
| EAN: |
9781407219912 |
| ISBN: |
9781407219912 |
| Kód |
D0008106 |
A homeless man in Boston, an Army Major in California, and a teenage girl in Atlanta all die suddenly and painfully - each a victim of an unknown doomsday virus. For three days, a team of scientists in a US government laboratory has been frantically trying to unlock the virus's secrets. Lt. Col. Jonathan 'Jon' Smith, a leading researcher from the lab, barely survives a series of well-orchestrated attempts made on his life. When he discovers that the virus has claimed its fourth victim, his fianc?e, he is devastated and enraged. Smith quickly uncovers evidence that his lover's death was no accident. But wherever he turns, some unseen force blocks his quest for information. Not knowing whom to trust, Smith assembles a private team to search for the truth behind the deadly virus. While the death toll mounts, their quest leads to the highest levels of power and the darkest corners of the earth, as they match wits with a determined genius - and as the future of the world lies in the balance.
| Způsob dopravy |
Cena |
Kdy zboží obdržím? |

|
Osobní odběr zásilkovna
Více než 200 poboček po ČR |
69 Kč*
|
Pozítří (ST)
|

|
Balík do ruky |
79 Kč*
|
Pozítří (ST)
|

|
PPL v České Republice |
95 Kč*
|
Pozítří (ST)
|

|
PPL na Slovensku |
199 Kč*
|
28.11.2025 (PÁ)
|
* K objednávce bude připočteno balné ve výši 10 Kč, cena za dobírku není zahrnuta v ceně.
Uvedené ceny jsou včetně DPH |
| Způsob platby |
Cena |

|
Twisto |
ZDARMA
|

|
Hotově na pobočce zásilkovna |
39 Kč
|

|
Bankovním převodem předem |
ZDARMA
|

|
Dobírka |
39 Kč
|